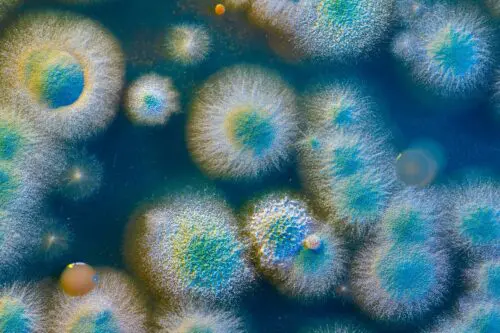
Fungal Antibodies Zoomer

Why Environmental Toxins Testing Matters
At Test Smartly Labs, we provide comprehensive environmental toxins testing to help individuals detect harmful exposures and take proactive steps to protect their health. Our testing services are available at multiple convenient locations across Kansas and Missouri.
Our Locations in Kansas & Missouri:
- Kansas City, MO
- Kansas City North, MO
- Overland Park, KS
- Independence, MO
- Belton - Raymore, MO
Find your nearest Test Smartly Labs location and schedule your environmental toxins test today.
Who Should Get Environmental Toxins Testing?
You may benefit from environmental toxins testing if you:
- Live or work in an area with high pollution, industrial chemicals, or mold exposure
- Experience chronic fatigue, brain fog, unexplained skin rashes, or digestive issues
- Have persistent respiratory problems, allergies, or sinus congestion
- Suspect exposure to mold, pesticides, heavy metals, or industrial toxins
- Work in industries such as construction, manufacturing, agriculture, or cleaning services
- Have had water damage or mold growth in your home or workplace
Even if you don’t have noticeable symptoms, routine environmental toxin screening can help detect hidden exposures before they lead to serious health issues.
Comprehensive Environmental Toxins Testing at Test Smartly Labs:
We offer specialized environmental toxin panels designed to assess exposure to various pollutants, chemicals, and fungal toxins.
1. Environmental Toxins Zoomer
This advanced test screens for a wide range of environmental toxins, including:
- Pesticides & Herbicides – Commonly found in food, water, and agricultural areas
- Industrial Pollutants – Heavy chemicals used in manufacturing, paints, and plastics
- Household Toxins – Exposure from cleaning products, personal care items, and building materials
- Airborne Pollutants – Chemicals found in smog, tobacco smoke, and vehicle exhaust
Best for: Individuals experiencing unexplained health issues or those living in high-exposure areas.
2. Fungal Antibodies Zoomer:
This test detects fungal infections and mold-related illnesses by identifying antibody reactions to common fungal toxins.
- Aspergillus & Penicillium – Mold species commonly found in water-damaged buildings
- Candida Overgrowth – Can cause digestive problems, fatigue, and immune dysfunction
- Black Mold (Stachybotrys) – Associated with severe respiratory issues and neurological symptoms
- Other Fungal Species – Exposure from contaminated food, air conditioning systems, and humid environments
Best for: Individuals with chronic sinus infections, asthma, autoimmune issues, or mold exposure concerns.
Symptoms of Environmental Toxin Exposure
Long-term exposure to environmental toxins and mold can contribute to a variety of symptoms, including:
Neurological Symptoms:
- Brain fog, memory loss, or difficulty concentrating
- Dizziness or frequent headaches
- Mood swings, anxiety, or depression
Respiratory & Allergy Symptoms:
- Chronic sinus congestion or sinus infections
- Persistent coughing or wheezing
- Asthma flare-ups or difficulty breathing
Skin & Digestive Issues:
- Unexplained skin rashes or hives
- Bloating, nausea, or irritable bowel symptoms
- Frequent yeast infections or food sensitivities
If you are experiencing any of these symptoms, environmental toxins testing can help identify the root cause and allow you to take steps to reduce exposure.
Why Choose Test Smartly Labs for Environmental Toxins Testing in Kansas & Missouri?
- Fast & Accurate Results – Most results available within 24–72 hours
- No Doctor’s Referral Needed – Walk-in testing available without a prescription
- Comprehensive Testing – Advanced screening for environmental chemicals, pollutants, and mold exposure
- Multiple Convenient Locations – Serving Kansas City, Kansas City North, Overland Park, Independence, and Belton - Raymore
- Confidential & Secure Testing – Your health information remains private and protected
Find your nearest Test Smartly Labs location and book your environmental toxins test today.
Protect Your Health – Get Tested for Environmental Toxins Today
Environmental toxins and mold exposure can have serious long-term health effects if left undetected. Whether you are experiencing symptoms or simply want peace of mind, getting tested is the best way to identify and manage toxic exposures before they cause serious health complications.
-
$389
Environmental Toxins Zoomer: A thorough panel of 39 of the most inflammatory environmental toxins detected in urine, including plasticizers, pesticides, and more. Specimen Type: Blood
-
$359
A comprehensive panel of antibodies to common and emerging fungal pathogens known to cause disease and inflammatory symptoms in humans. Your tests comes with a comprehensive results report. Specimen Type: Blood This is ONLY available Monday - Friday, 9am - 3pm. NO SATURDAYS
-
$599
The most comprehensive panel for detection of exposure to mycotoxins, with 28+ markers measured to the most toxic molds and mycotoxins. This test includes a comprehensive results report in an easy to read format. Specimen Type Blood
-
$849
This ultimate toxins panel for 28+Mycotoxins (Mold), 20+Heavy Metals, and 38+ Environmental Chemicals. This panel is designed to find the potential causes of toxicity-related symptoms. A comprehensive panel for those who want to cover all the bases.